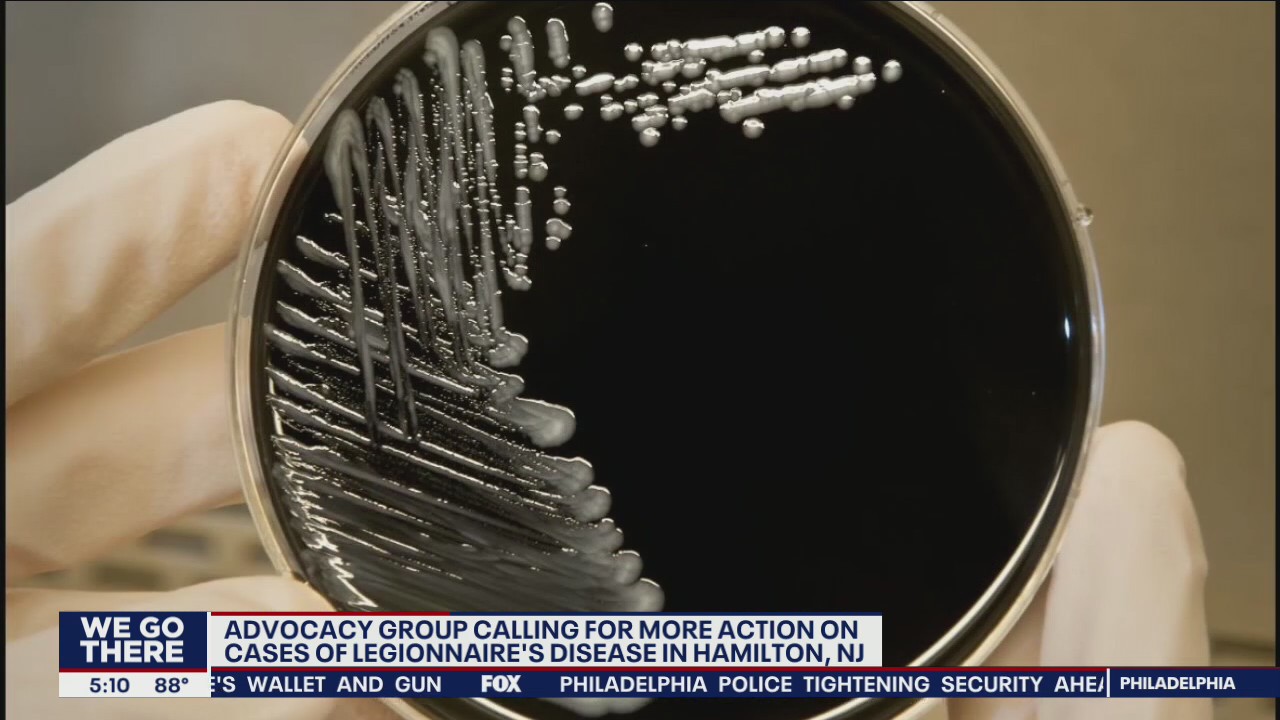
N.J. health officials investigate Legionnaire's Disease cases in Mercer County

Search continues for Princeton University student missing for nearly one week
The search for a missing Princeton University student continues as Friday marks one week since her disappearance.
The search for a missing Princeton University student continues as Friday marks one week since her disappearance.
Philadelphia city leaders travel to Trenton for Violence Reduction Summit
Philadelphia and Trenton city leaders meet to talk about how to reduce violence.
Philadelphia and Trenton city leaders meet to talk about how to reduce violence.
Trenton police investigate early morning shooting that injured 2 people
According to officials, the shooting happened early Sunday morning, around 4 a.m., on the 1000 block of Genesee Street.
According to officials, the shooting happened early Sunday morning, around 4 a.m., on the 1000 block of Genesee Street.
Roof of Ewing Senior and Community Center collapsed as crews battled 3-alarm fire
The roof of the Ewing Senior and Community Center has collapsed as crews battled a three-alarm fire that broke out Friday morning.
The roof of the Ewing Senior and Community Center has collapsed as crews battled a three-alarm fire that broke out Friday morning.
Roof of Ewing Senior and Community Center collapsed as crews battled 3-alarm fire
According to fire officials, the roof of the building collapsed as crews worked to put out the flames. The cause of the fire remains under investigation.
According to fire officials, the roof of the building collapsed as crews worked to put out the flames. The cause of the fire remains under investigation.
Officials: Man, 31, fatally shot to death inside car in Trenton
Officials say a 31-year-old man has died after he was found in the driver's seat of a car with several gunshot wounds to his chest.
Officials say a 31-year-old man has died after he was found in the driver's seat of a car with several gunshot wounds to his chest.
Mercer County high school teacher accused of having sexual relationship with student
A New Jersey high school teacher and coach was arrested after prosecutors say he had an inappropriate sexual relationship with a student.
A New Jersey high school teacher and coach was arrested after prosecutors say he had an inappropriate sexual relationship with a student.
Recent Mercer County uptick in Legionnaire's Disease cases to be investigated by health officials
Recent studies show the bacteria that causes Legionnaire's Disease is in the water in half of all households in Hamilton.
Recent studies show the bacteria that causes Legionnaire's Disease is in the water in half of all households in Hamilton.
N.J. health officials investigate Legionnaire's Disease cases in Mercer County
A recent increase in Legionnaire's Diseases in Hamilton, N.J. has health officials concerned.
A recent increase in Legionnaire's Diseases in Hamilton, N.J. has health officials concerned.
Pete Carril, old-school Princeton coaching maestro, dies
The old-school Princeton basketball coach Pete Carril died at the age of 92 on Monday, according to a statement from his family.
The old-school Princeton basketball coach Pete Carril died at the age of 92 on Monday, according to a statement from his family.
Trenton homicide suspect arrested, charged 8 years after man's shooting death, authorities say
Police say the 40-year-old Trenton man was arrested and charged eight years after the fatal shooting on July 19, 2014.
Police say the 40-year-old Trenton man was arrested and charged eight years after the fatal shooting on July 19, 2014.
Officials: Good Samaritan helps safely evacuate Trenton house fire
Officials credited a Good Samaritan for running into a Trenton house fire and helping people inside safely evacuate the burning home.
Officials credited a Good Samaritan for running into a Trenton house fire and helping people inside safely evacuate the burning home.
Officials: 4-year-old boy drowns in Mercer County lake
Responding officers made an extensive search and, about an hour later, they located the child submerged in Spring Lake, inside John Roebling Memorial Park.
Responding officers made an extensive search and, about an hour later, they located the child submerged in Spring Lake, inside John Roebling Memorial Park.
NJ State Police announce 8 arrested, charged in Mercer County human trafficking ring
New Jersey State Police announced the arrest of eight individuals Wednesday, along with the dismantling of the ring, as a part of a four-month investigation.
New Jersey State Police announced the arrest of eight individuals Wednesday, along with the dismantling of the ring, as a part of a four-month investigation.
Person rescued from trench in Hamilton Township
Rescue crews worked frantically to get the person out of the space that person was trapped in.
Rescue crews worked frantically to get the person out of the space that person was trapped in.
Person rescued from trench in Hamilton Township
Rescue crews worked frantically to get the person out of the space that person was trapped in.
Rescue crews worked frantically to get the person out of the space that person was trapped in.
New Jersey Assembly advances bill raising firearm purchase age to 21
New Jersey would change the age for purchasing rifles and shotguns from 18 to 21 under legislation an Assembly committee has advanced.
New Jersey would change the age for purchasing rifles and shotguns from 18 to 21 under legislation an Assembly committee has advanced.
Police: Man sought in attempted sexual assault of teen girl in Princeton
Authorities in New Jersey are searching for a man who allegedly tried to grab a teenage girl's buttocks as she entered her car.
Authorities in New Jersey are searching for a man who allegedly tried to grab a teenage girl's buttocks as she entered her car.
Mercer County Prosecutor: Teen, 16, dies after being found on Trenton street with multiple stab wounds
Authorities say the teen was found in the street with multiple stab wounds and he was pronounced dead at the hospital on Wednesday.
Authorities say the teen was found in the street with multiple stab wounds and he was pronounced dead at the hospital on Wednesday.
Statue stolen near Trenton church found at Philadelphia scrapyard, police say
A bronze statue stolen near a New Jersey church was found days later at a scrapyard in Philadelphia, according to police.
A bronze statue stolen near a New Jersey church was found days later at a scrapyard in Philadelphia, according to police.